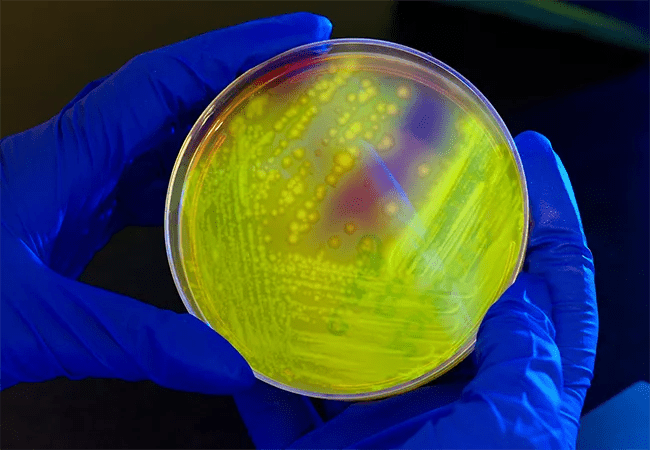

Two types of medications appear to be culprits
Image content: This image is available to view online.
View image online (https://assets.clevelandclinic.org/transform/8f453b82-5be6-4037-b3e8-760ee15fbc82/650x450-Clostridium-difficile_png)
650×450 Clostridium difficile
Prior exposure to antibiotics and proton pump inhibitors are associated with an increased risk of acquiring Clostridioides (formerly Clostridium) difficile infection (CDI) among hospitalized children, according to new Cleveland Clinic research.
Advertisement
Cleveland Clinic is a non-profit academic medical center. Advertising on our site helps support our mission. We do not endorse non-Cleveland Clinic products or services. Policy
Additional high-quality epidemiologic studies are needed to validate the results and explore other potential risk factors. But the findings are an important reminder that clinicians should be cautious about prescribing antibiotics and proton pump inhibitors to pediatric inpatients so as to minimize the threat of hospital-acquired CDI, says study coauthor Charles Foster, MD, of Cleveland Clinic Children’s Center for Pediatric Infectious Diseases.
C. difficile is a Gram-positive, spore-forming bacterium that produces toxins that cause intestinal inflammation and damage to the intestinal cells, resulting in mild to severe diarrhea. It is resistant to many common antibiotics.
CDI is a growing concern among hospitalized children and has been associated with significantly worsened outcomes, including lengthened hospital stays, added hospital costs and increased morbidity and mortality. The emergence of the epidemic hypervirulent BI/NAP1/027 C. difficile strain has heightened the incidence of infection among pediatric inpatients in the last two decades.
Previous antibiotic exposure and proton pump inhibitor use, among others, are known CDI risk factors in adult patients. CDI risk factors in children are less clear, however, and are confounded by the fact that C. difficile bacteria often are detected in the stool of infants but rarely cause disease in children less than 2 years of age.
Dr. Foster and his collaborators undertook a systematic review of the literature and meta-analysis in an attempt to evaluate the risk factors among hospitalized children for developing CDI. They screened multiple studies published from 1975 to 2017, ultimately selecting 14 relevant articles that focused on risk factors for developing CDI among hospitalized children. The 14 studies encompassed 10.5 million children, of which 22,320 developed CDI. The studies represented patients in the United States, Italy, Canada, China, Croatia, Japan, Spain and Turkey.
Advertisement
The results of the meta-analysis suggested that prior antibiotic exposure and proton pump inhibitor use were associated with an increased risk of CDI in children.
Specifically, hospitalized children with prior antibiotic exposure had twice the risk of developing CDI compared to children without recent antibiotic exposure.
However, because of the limited number of relevant available studies, the meta-analysis could not evaluate the risk of specific antibiotics, and the increased risk was not statistically significant after pooling only adjusted studies. It is likely that antibiotic exposure alters the gut microbiota, decreasing the resistance to C. difficile colonization.
Four studies examined proton pump inhibitor use as a CDI risk factor among hospitalized children. Meta-analysis of those studies demonstrated a significantly elevated risk of CDI among pediatric inpatients. Proton pump inhibitors are also known to alter the gut microenvironment by suppressing gastric acid production. Previous research examining possible proton pump inhibitor-CDI associations has not been definitive, but a linkage is biologically plausible because loss of acidity can disrupt normal gastrointestinal microbial diversity and prolong C. difficile spore survival, increasing CDI susceptibility in children.
More high-quality studies are necessary to confirm the Cleveland Clinic study’s findings and to evaluate possible additional CDI risk factors in pediatric inpatients. Clinicians should continue to judiciously use antibiotics to reduce CDI risk in their hospitalized pediatric patients, and observe similar careful administration of proton pump inhibitors, Dr. Foster says.
Advertisement
Advertisement
Try these moves to relieve butt pain and numbness
Systemic change needed to improve health outcomes for parents and children, say researchers
Rare genetic variant protected siblings against seizures and severe hypoglycemia
Movie has more positive impact than expected, says Head of Adolescent Medicine
Genetic changes are similar between some vascular anomalies and cancers
Expert panel advises a two-tier structure for surgical centers
Our new head of pediatric general and thoracic surgery shares his passion and vision
Basic understanding of condition and treatment is lacking